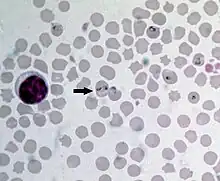

Babesia bovis
| Babesia bovis | |
|---|---|
![]() | |
| Scientific classification | |
| Domain: | Eukaryota |
| Clade: | Diaphoretickes |
| Clade: | SAR |
| Clade: | Alveolata |
| Phylum: | Apicomplexa |
| Class: | Aconoidasida |
| Order: | Piroplasmida |
| Family: | Babesiidae |
| Genus: | Babesia |
| Species: | B. bovis |
| Binomial name | |
| Babesia bovis V. Babes 1888 | |
| Synonyms | |
| |
Babesia bovis is an Apicomplexan single-celled parasite of cattle which occasionally infects humans. The disease it and other members of the genus Babesia cause is a hemolytic anemia known as babesiosis and colloquially called Texas cattle fever, redwater or piroplasmosis. It is transmitted by bites from infected larval ticks of the order Ixodida.[1] It was eradicated from the United States by 1943, but is still present in Mexico and much of the world's tropics. The chief vector of Babesia species is the southern cattle fever tick Rhipicephalus microplus (formerly Boophilus microplus).[2]
In 2007, the sequence of its genome was announced. Measuring 8.2 million base pairs, its genome is remarkably similar to the genome of Theileria parva, the cause of East Coast fever (theileriosis) in cattle.[3]
Infection
Babesia bovis is transmitted transovarially, from the female ticks to the eggs, and can remain resident in tick populations for up to four years without infecting a vertebrate host. More commonly, a larval tick feeds upon a domestic cow, an African buffalo or a water buffalo, releasing the parasites into the animal's bloodstream. The involvement of the larval stage of the ticks in the cycle is specific to B. bovis; other Babesia species only involve adult ticks. The parasites then invade individual red blood cells, multiplying and destroying the host cells until the animal is stricken with hemolytic anemia.[1] Adult ticks which feed upon infected cattle are infected themselves, completing the cycle. In humans, infection is rare and usually only affects splenectomized patients.[4]
See also
References
- 1 2 Spickler, Anna Rovid; James A. Roth (2008). Emerging and exotic diseases of animals. Ames, Iowa: Institute for International Cooperation in Animal Biologies. p. 132. ISBN 978-0-9745525-5-2.
- ↑ Mullen, Gary R.; Lance A. Durden (2009). Medical and Veterinary Entomology. Elsevier Science. p. 500. ISBN 978-0-12-372500-4.
- ↑ Brayton KA, Lau AO, Herndon DR, et al. (2007). "Genome Sequence of Babesia bovis and Comparative Analysis of Apicomplexan Hemoprotozoa". PLOS Pathogens. 3 (10): 1401–13. doi:10.1371/journal.ppat.0030148. PMC 2034396. PMID 17953480.
- ↑ Gelfand, Jeffrey A.; Vannier, Edouard. Harrison's Principles of Internal Medicine, 17th ed. McGraw-Hill’s Access Medicine. ISBN 978-0-07-146633-2.
External links
- Current status of Bovine babesiosis worldwide at OIE. WAHID Interface - OIE World Animal Health Information Database
- Disease card